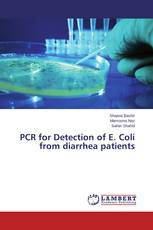
PCR for Detection of E. Coli from diarrhea patients

Sorry, Something is wrong with your request
Оценочные категории в международном публичном и частном праве
Виталий Воробьев - ISBN: 978-3-659-69869-9
Translation of English Simple Texts
For English Translation Students
Hajar Shahhoseiny - ISBN: 978-3-659-69890-3
Live in Relationship & Hindu Marriage
A Critical Legal Analysis
Jayanta Ghosh - ISBN: 978-3-659-69993-1
PCR for Detection of E. Coli from diarrhea patients
Shaista Bashir, Mamoona Naz, Saher Shahid - ISBN: 978-3-659-70680-6
Организация олимпиад по русскому языку
Содержательный аспект
Ю.Г. Смирнова - ISBN: 978-3-659-70630-1
THE KASHMIR CONFLICT: Attitude of general public towards police
Omar Habib, Urfain Habib, Shahid Ali - ISBN: 978-3-659-69244-4